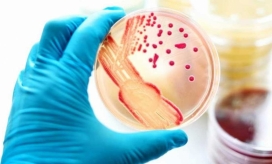
La gonorrea afecta a más de 70 millones de personas en el mundo.

La determinación unánime de la Fundación del Festival de la Leyenda Vallenata de dedicar el quincuagésimo primer festival, que se realizará del 26 al 30 de abril de 2018, al cantante samario Carlos Vives ha despertado reacciones contrariadas entre otros artistas vallenatos.